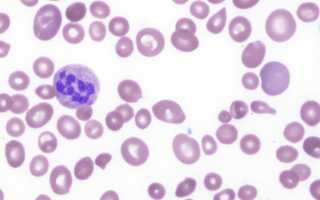

В чем сходство и в чем отличие
Как уже упоминалось, анемии, связанные с дефицитом витамина В12 и фолиевой кислоты, относятся к мегалобластным анемиям. Эти состояния характеризуются снижением синтеза ДНК, что приводит к нарушению деления клеток, способных к быстрому размножению. К таким клеткам относятся:
- Клетки костного мозга;
- Клетки кожных покровов;
- Клетки слизистых оболочек;
- Клетки желудочно-кишечного тракта.
Среди быстро делящихся клеток гемопоэтические (кроветворные) клетки имеют наибольшую предрасположенность к ускоренному размножению. Поэтому симптомы анемии становятся одними из первых клинических проявлений мегалобластных анемий. Часто, помимо анемии (снижения уровня эритроцитов и гемоглобина), наблюдаются и другие признаки гематологических нарушений, такие как уменьшение количества тромбоцитов (тромбоцитопения), нейтрофилов (нейтропения, агранулоцитоз), а также моноцитов и ретикулоцитов.
Почему эти виды анемии взаимосвязаны и в чем их отличие? Дело в следующем:
- Витамин В12 играет ключевую роль в образовании тимидина, необходимого для синтеза ДНК. Это взаимодействие с участием всех необходимых компонентов обеспечивает нормальное формирование клеток крови и клеток желудочно-кишечного тракта.
- Витамин В12 также участвует в процессах распада и синтеза отдельных жирных кислот. При недостатке цианокобаламина этот процесс нарушается, что приводит к накоплению метилмалоновой кислоты, вредной для нейронов. В результате снижается продукция миелина — вещества, образующего миелиновую оболочку, которая выполняет электроизолирующую функцию для нервных клеток.
Фолиевая кислота не требуется для распада жирных кислот, и при ее недостатке нервная система не страдает. Более того, если пациенту с дефицитом В12 назначить фолиевую кислоту, она может временно стимулировать эритропоэз, но только до тех пор, пока не начнет накапливаться в избытке. Избыточное количество препарата заставляет использовать весь имеющийся в организме В12, включая тот, который необходим для распада жирных кислот. Это приводит к негативным последствиям: ухудшается состояние нервных тканей, развиваются серьезные дегенеративные изменения в спинном мозге, что может привести к потере двигательных и чувствительных функций (комбинированный склероз, фуникулярный миелоз).
Таким образом, нехватка витамина В12, помимо нарушения деления кроветворных клеток и развития анемии, негативно сказывается на нервной системе. Дефицит фолиевой кислоты влияет только на деление гемопоэтических клеток и не затрагивает здоровье нервной системы.
Врачи отмечают, что В12-дефицитная анемия и В12-фолиеводефицитная анемия имеют схожие проявления, такие как усталость, слабость и бледность кожи. Основные причины этих состояний включают недостаток витамина B12, который может возникать из-за неправильного питания, нарушений всасывания или аутоиммунных заболеваний, а также дефицит фолиевой кислоты, часто связанный с недостаточным потреблением овощей и фруктов. Диагностика включает анализы крови на уровень витаминов и определение показателей гемоглобина. Лечение обычно предполагает назначение витаминов в инъекциях или таблетках, а также коррекцию рациона. Важно, чтобы пациенты своевременно обращались к специалистам для предотвращения осложнений, связанных с этими анемиями.

Значимость внутреннего фактора
Цианокобаламин, поступающий из пищи в желудочно-кишечный тракт, усваивается с помощью внутреннего фактора (ВФ). Процесс усвоения выглядит следующим образом:
- В желудке витамин B12 связывается с белком R, образуя комплекс «Vit B12 + protein-R». Этот комплекс направляется в двенадцатиперстную кишку, где под воздействием протеолитических ферментов происходит его расщепление.
- В двенадцатиперстной кишке цианокобаламин освобождается от белка R и взаимодействует с внутренним фактором, образуя новый комплекс – «Vit B12 + ВФ».
- Комплекс «Vit B12 + ВФ» перемещается в тощую кишку, связывается с рецепторами для внутреннего фактора и всасывается.
- После всасывания цианокобаламин связывается с транспортным белком транскобаламин II, который доставляет его в места использования или в депо (костный мозг, печень).
Внутреннему фактору уделяется особое внимание, так как при его нормальном функционировании почти весь цианокобаламин, поступивший с пищей, достигает своей цели. В противном случае (при отсутствии ВФ) лишь 1% витамина B12 сможет пройти через стенку кишечника, и человек не получит необходимое количество этого важного витамина.
Суточная потребность организма в цианокобаламине составляет от 3 до 5 мкг, а запасы варьируются от 4 до 5 граммов. Таким образом, можно подсчитать, что при полном исключении витамина B12 (например, после гастрэктомии) запасы иссякнут через 3-4 года. В целом, запас витамина B12 рассчитан на 4-6 лет, в то время как фолиевая кислота при отсутствии поступления может исчезнуть за 3-4 месяца. Это позволяет сделать вывод, что дефицит В12 во время беременности не представляет угрозы, если до этого его уровень был в норме. Однако фолиевая кислота, если женщина не употребляла сырых фруктов и овощей, может упасть ниже допустимого уровня и вызвать дефицитное состояние (развитие фолиеводефицитной анемии).
Витамин B12 содержится в продуктах животного происхождения, тогда как фолиевая кислота присутствует практически во всех продуктах питания. Цианокобаламин хорошо переносит длительную термическую обработку и сохраняется для усвоения организмом, в отличие от фолиевой кислоты, которая теряет свои свойства уже после 15 минут кипячения.
| Признак | Дефицит витамина B12 | Дефицит витамина B12 и фолиевой кислоты |
|---|---|---|
| Причины | Аутоиммунное заболевание (пернициозная анемия), гастрэктомия, вегетарианство/веганство (недостаточное потребление), синдром мальабсорбции (болезнь Крона, целиакия), лекарственные препараты (метформин), старение | Комбинация причин дефицита B12 и фолиевой кислоты (см. выше для B12, недостаточное потребление фолиевой кислоты, повышенная потребность (беременность), лекарственные препараты (метотрексат), нарушения всасывания фолиевой кислоты |
| Проявления | Утомляемость, слабость, одышка, бледность кожи, тахикардия, онемение и покалывание в конечностях (парестезии), нарушение координации движений, потеря памяти, депрессия, глоссит (воспаление языка), мегалобластная анемия | Подобны проявлениям дефицита B12, но могут быть менее выражены на ранних стадиях. Неврологические симптомы могут быть менее выраженными, чем при изолированном дефиците B12. |
| Диагностика | Анализ крови (снижение уровня витамина B12, мегалобластная анемия, повышенный уровень гомоцистеина и метилмалоновой кислоты), исследование желудочной секреции (для выявления пернициозной анемии), исследование костного мозга | Анализ крови (снижение уровня витамина B12 и фолиевой кислоты, мегалобластная анемия, повышенный уровень гомоцистеина), исследование костного мозга |
| Лечение | Пероральные или инъекционные препараты витамина B12 (цианкобаламин), доза и способ введения зависят от причины и тяжести дефицита | Пероральные или инъекционные препараты витамина B12 и фолиевой кислоты, доза и способ введения зависят от причины и тяжести дефицита |
В чем причина дефицита этих витаминов?
Недостаток цианокобаламина может возникать по нескольким причинам:
-
Недостаточное поступление витамина В12 с пищей. Это происходит, когда человек не получает достаточное количество продуктов, содержащих цианокобаламин, таких как мясо, печень, яйца и молочные изделия. Полный переход на вегетарианство также может привести к дефициту, так как в растительной пище витамин В12 практически отсутствует.
-
Нарушение выработки внутреннего фактора. Это может быть связано с атрофией слизистой оболочки, которая развивается из-за наследственной предрасположенности, воздействия токсичных веществ, действия антител или атрофического гастрита. Проблемы могут возникнуть у пациентов после полной гастрэктомии, тогда как частичное удаление желудка обычно не затрагивает секрецию.
-
Отсутствие рецепторов для связывания внутреннего фактора. Это происходит при заболеваниях, поражающих желудочно-кишечный тракт, таких как болезнь Крона, дивертикулез, опухоли тонкой кишки, туберкулез и резекция подвздошной кишки, а также при кишечном инфантилизме (целиакия) и хроническом энтерите.
-
Конкуренция за усвоение цианокобаламина в ЖКТ. Гельминты или микроорганизмы могут поглощать витамин, особенно после хирургических вмешательств, таких как наложение анастомозов.
-
Нарушение внешнесекреторной функции поджелудочной железы. Это может привести к проблемам с расщеплением протеина-R, что затрудняет связывание витамина В12 с внутренним фактором.
-
Редкая наследственная аномалия. Она проявляется в снижении уровня транскобаламина и нарушении транспортировки цианокобаламина в костный мозг.
Что касается витамина В9, то он содержится практически во всех продуктах, хорошо усваивается в здоровом кишечнике и не требует наличия внутреннего фактора. Проблемы с его усвоением могут возникнуть в следующих случаях:
- Питание пациента крайне ограничено;
- Человек с нервной анорексией отказывается от пищи;
- Пациент пожилого возраста;
- Алкоголик страдает от абстинентного синдрома после длительного запоя и не может полноценно питаться;
- Имеется синдром нарушенного всасывания в кишечнике (болезнь Крона, целиакия, опухоли кишечника и др.);
- Увеличенная потребность в фолиевой кислоте, что наблюдается при беременности, некоторых кожных заболеваниях (псориаз, дерматит) и нарушениях обмена (алкоголизм, врожденные болезни обмена фолатов).
Дефицит витамина В9 часто встречается у людей, которые длительное время принимают противосудорожные препараты, такие как фенобарбитал. Это следует учитывать при назначении подобной терапии.
В12-дефицитная анемия и В12-фолиеводефицитная анемия — это состояния, которые часто обсуждаются в медицинских кругах и среди пациентов. Основные причины этих анемий связаны с недостаточным поступлением витамина B12 и фолиевой кислоты в организм, что может быть вызвано неправильным питанием, нарушением всасывания или определёнными заболеваниями. Симптомы включают усталость, слабость, головокружение, а также неврологические проявления, такие как онемение и покалывание в конечностях. Диагностика обычно включает анализы крови на уровень витаминов и других показателей. Лечение может включать инъекции витамина B12 или добавление фолиевой кислоты в рацион. Важно помнить, что ранняя диагностика и адекватное лечение могут значительно улучшить качество жизни пациентов и предотвратить серьёзные осложнения.

Как проявляются В12- и В9-дефицитные состояния?
Если говорить о состояниях, связанных с анемиями, то они сопровождаются признаками малокровия:
- Быстрая утомляемость даже при незначительных физических нагрузках, общая слабость и снижение работоспособности.
- Эпизоды потемнения в глазах.
- Склонность к гипотонии (понижению артериального давления).
- Проблемы с дыханием: одышка при ускорении шага или выполнении других движений.
- Периодические головные боли и частые головокружения.
- Нарушение сердечного ритма (тахикардия).
- Бледная кожа с легким желтоватым оттенком (субиктеричность).
- Проблемы в полости рта, характерные для глоссита: атрофия сосочков, лакированная поверхность языка, его отечность и болезненность.
- Возможное увеличение печени и селезенки.
- Отечность ног.
- Частый стул, чередующийся с запорами.
- Заметное снижение аппетита и, как следствие, потеря веса.
При недостатке цианокобаламина наблюдается триада синдромов: поражение крови, желудочно-кишечного тракта и нервной системы. При дефиците фолиевой кислоты нарушения нервной системы не фиксируются. Симптомы, указывающие на вовлечение нервной системы в патологический процесс, включают:
- Фуникулярный миелоз (дегенеративное заболевание спинного мозга), степень выраженности которого не всегда соответствует клиническим проявлениям анемии.
- Периферическая полинейропатия, проявляющаяся мышечной слабостью, нарушением чувствительности и снижением сухожильных рефлексов.
- В некоторых случаях на фоне анемии могут возникать депрессивные состояния, проблемы с памятью и, реже, психические расстройства.
Важно отметить, что состояния, связанные с дефицитом витамина B12 и фолиевой кислоты, не прогрессируют быстро и не имеют ярко выраженных симптомов. Ранее эти заболевания считались характерными для пожилых людей, однако в последние годы наблюдается тенденция к «омоложению» — такие анемии стали встречаться и у молодежи.
Диагностика
Клинические проявления желтушности склер и кожи сигнализируют о необходимости немедленной отправки пациента на лабораторные исследования для диагностики состояний, связанных с дефицитом фолиевой кислоты и витамина B12.
Первый этап лабораторной диагностики может указывать на наличие мегалобластной анемии:
- Общий анализ крови (ОАК) показывает характерные изменения: снижение уровня эритроцитов и гемоглобина, тромбоцитопения, нейтропения с полисегментированностью. ЦП обычно превышает 1, наблюдаются макроцитоз, пойкилоцитоз и анизоцитоз. В эритроцитах могут быть обнаружены тельца Жолли и кольца Кебота.
- В биохимическом анализе крови (БАК) фиксируются повышенные уровни билирубина, в основном за счет несвязанной фракции.
Важно отметить, что аналогичные изменения в периферической крови могут быть вызваны другими гематологическими заболеваниями, такими как гипопластические и апластические состояния, гемолитическая анемия или лейкоз. Поэтому пациенту обязательно назначают пункцию спинного мозга, где можно обнаружить мегалобласты (характерный признак анемии, связанной с дефицитом витамина B12), а также гигантские мегакариоциты и клетки гранулоцитарного ряда.
После лабораторных исследований (или одновременно с ними) пациента ожидает «неприятная процедура» – фиброгастроскопия (ФГС). Результаты ФГС показывают атрофию слизистой оболочки желудка.
Крайне важно тщательно собрать анамнез пациента: изучить его образ жизни и питание, детально выявить симптомы, а также оценить состояние сердечно-сосудистой и нервной систем. Тем не менее, для окончательного уточнения диагноза необходимы лабораторные исследования. Следует подчеркнуть, что дифференциальная диагностика этих двух видов анемии представляет сложность для большинства лабораторий, так как требуется определение количественных значений витаминов. Однако:
- Микробиологические методы не идеальны и дают лишь ориентировочные результаты.
- Радиоиммунологические исследования недоступны для жителей сельских районов и небольших городов, так как их проведение требует современного оборудования и высокочувствительных реагентов, доступных только в крупных городах.
В таких случаях для дифференциальной диагностики может быть полезен анализ мочи, который определяет уровень метилмалоновой кислоты. При анемии, связанной с дефицитом витамина B12, ее содержание значительно увеличивается, в то время как при фолиевом дефиците уровень остается на прежнем уровне.

Лечение
Лечение дефицита фолиевой кислоты в основном включает назначение таблеток витамина В9 в дозировке от 5 до 15 мг в сутки. Если диагноз фолиеводефицитной анемии неясен, рекомендуется начать терапию с внутримышечного введения цианокобаламина. Важно помнить, что при В12-дефицитной анемии применение фолиевой кислоты может усугубить состояние.
Лечение В12-дефицитной анемии основывается на трех ключевых принципах:
- Полное насыщение организма цианокобаламином для выполнения всех функций и создания запасов.
- Регулярное пополнение запасов с помощью поддерживающих доз.
- Предотвращение развития анемии.
Основным аспектом терапии недостатка В12 является назначение цианокобаламина с учетом изменений в крови и наличия неврологических симптомов.
- Обычно лечение начинается с внутримышечного введения цианокобаламина в дозе 500 мкг ежедневно и оксикобаламина – 1000 мкг через день.
- При выраженных симптомах поражения нервной системы (фуникулярный миелоз) дозу В12 увеличивают до 1000 мкг ежедневно и добавляют 500 мкг аденозилкобаламина в таблетках, который участвует в обмене, но не влияет на кроветворение.
- Если в анализах крови наблюдается гипохромия эритроцитов на фоне лечения или при смешанных формах анемии (В12- + железодефицитная анемия), это служит основанием для назначения препаратов железа.
- Переливание эритроцитной массы проводится при явных признаках кислородного голодания головного мозга, симптомах анемической энцефалопатии, прогрессирующей сердечной недостаточности и при подозрении на другие осложнения.
- Параллельно назначается терапия, направленная на устранение причин дефицита витамина В12, включая дегельминтизацию (в зависимости от типа гельминтов), лечение заболеваний желудочно-кишечного тракта, хирургическое вмешательство при раке желудка, нормализацию кишечной флоры и разработку диеты, обеспечивающей достаточное поступление витамина B12.
Через несколько дней после начала лечения проводится контрольный подсчет ретикулоцитов, что подтверждает правильность выбранной тактики.
Когда состояние крови нормализуется, пациента переводят на поддерживающую терапию: сначала каждые семь дней, а затем раз в месяц вводят 500 мкг В12. Также раз в полгода назначают 2-3 недельный курс витаминотерапии (поддерживающее лечение витамином В12).
Продукты, богатые витамином В12 (только для профилактики анемий, связанной с недостатком цианокобаламина в пище):
Видео: о дефиците витамина В12, программа “Жить здорово”
Вопрос-ответ
Что характерно для В12-фолиеводефицитной анемии?
Комментарии: характерным диагностическим признаком В12-дефицитной анемии служит повышенная клеточность костного мозга и обилие мегалобластов, которые зачастую имеют причудливую форму ядра.
Каковы причины В12-дефицитной анемии?
В12-дефицитная анемия возникает в результате недостатка витамина B12, который может быть вызван различными факторами, включая недостаточное поступление витамина с пищей (например, у вегетарианцев и веганов), нарушения всасывания в кишечнике (например, при болезни Крона или целиакии), а также аутоиммунные заболевания, такие как пернициозная анемия, при которых организм вырабатывает антитела к клеткам, производящим внутренний фактор, необходимый для усвоения витамина B12.
Какую болезнь вызывает недостаток витамина В12?
При дефиците витамина В12 может развиваться мегалобластная анемия, признаки которой можно обнаружить в клиническом анализе крови. Симптомы со стороны нервной системы: чаще всего онемение конечностей, парестезии, нарушение походки.
Каковы причины фолиеводефицитной анемии?
Фолиеводефицитная анемия возникает из-за недостатка фолиевой кислоты, необходимой для синтеза ДНК и образования красных кровяных клеток. Основные причины включают недостаточное поступление фолата с пищей (например, при неправильном питании или алкоголизме), нарушения всасывания в кишечнике (при заболеваниях, таких как целиакия или болезнь Крона), а также повышенные потребности организма в фолате (например, во время беременности или при быстром росте).
Советы
СОВЕТ №1
Регулярно проверяйте уровень витамина B12 и фолата в крови, особенно если вы находитесь в группе риска (вегетарианцы, пожилые люди, беременные женщины). Это поможет своевременно выявить дефицит и начать лечение.
СОВЕТ №2
Обратите внимание на свой рацион. Включайте в него продукты, богатые витамином B12 (мясо, рыба, молочные продукты) и фолиевую кислоту (зеленые листовые овощи, бобовые, орехи). Это поможет предотвратить развитие анемии.
СОВЕТ №3
Если у вас уже диагностирована В12-дефицитная анемия, следуйте рекомендациям врача по лечению. Это может включать инъекции витамина B12 или прием добавок, чтобы восстановить уровень витамина в организме.
СОВЕТ №4
Обратите внимание на симптомы анемии, такие как усталость, слабость, головокружение и бледность кожи. При их появлении не откладывайте визит к врачу для диагностики и возможного лечения.